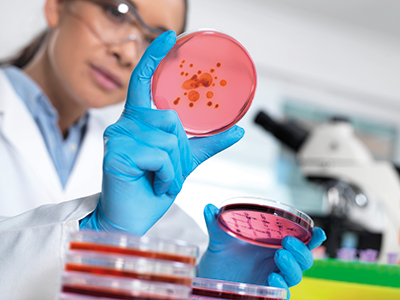
微生物培养基用于检测食品和水样污染情况

EN ISO 11133和制备用水和微生物培养基性能测试
中央纯化去离子水与自动化纯水系统对比
EN ISO 11133标准建立了确保培养基质量的环境,并规定了培养基在用于食品、动物饲料和水的微生物分析时的制备要求。1为了符合这一标准,整个流程的每个要素都必须满足特定要求。
因为水是微生物培养基中体积最大的成分,所以水有可能会影响培养基的性能。本研究的目的是使用来自两种水源的水,根据EN ISO 11133 制备培养基和测试其性能。
用于制备培养基的水源
将脱水培养基溶于以下两种不同来源的水中,一式两份制备每种培养基:
- 实验室中现成可用的去离子水:该去离子水由中央供水系统结合反渗透、离子交换和紫外线杀菌等纯水技术制成并通过分配回路将水输送到实验室。根据EN ISO 11133标准的要求(表1),在整个研究过程中,水的电导率一直保持在2 µS/cm以下,微生物水平< 102 cfu/mL。
- Milli-Q® IX 7003纯水系统产出的水:该系统安装于实验室内并直接连接到自来水,并结合了多种纯水技术来提供纯水:反渗透、Elix®电去离子和UVC LED杀菌灯。新鲜的纯水从系统的E-POD®取水臂取用,取水臂安装有Millipak® 0.22 µm过滤器,以确保低微生物水平。该系统经过验证,可以在25 °C下输送电导率 < 0.2 µS/cm 但通常为0.1 µS/cm(相当于电阻率 > 5 MΩ.cm,通常为10-15 MΩ.cm)且微生物水平 < 102 cfu/mL的水,符合ISO 11133标准1 要求(表1)。
培养基制备
为了获得具有代表性的结果,本研究共选用了七种不同的脱水培养基(表2)。性能测试使用的所有培养基均符合相应的EN ISO/FDA细菌分析手册(BAM)/USDA-FSIS/APHA以及其他标准和方法要求。表3中列出了规定培养基的相应标准以及规定这些培养基相关性能测试的标准,另外还列出了对照菌株、WDCM和ATCC®(美国标准生物品典藏中心)编号。
培养基均按照制造商的说明制备。具体而言,将所需重量的脱水培养基添加到500 mL的中央纯化去离子水或Milli-Q® IX产水中。所有培养基均被溶解、加热,并视需要根据制造商的说明被高压灭菌。
本研究由德国达姆施塔特Merck生命科学微生物产品质量控制(QC)实验室进行。该实验室已获得德国认证权威机构DAkkS的认证,并被注册为经过DIN EN ISO / IEC 170252 认证的测试实验室,有资格根据DIN EN ISO 11133进行微生物培养基性能测试。
制备的微生物培养基性能测试
按照EN 11113标准1 所述的定量或定性方法,评估了生长和抑制情况。
- 繁殖率是指在规定条件下从培养基中回收靶标微生物的水平。
- 选择性是指在规定条件下,在选择性培养基之上或之中抑制非靶标微生物的程度。
- 特异性是指在规定条件下,非靶标生物即使能够在培养基上生长,也不会显示出与靶标微生物相同的视觉特征。
1.细菌、酵母和霉菌的制备与接种
对照菌株均从ATCC®获得,并根据EN ISO 11133标准和/或其他特定标准的要求甄选。它们被稀释至所需数量的微生物以便接种,用于测试繁殖率、特异性和选择性。性能评估和结果解释均根据EN ISO 11133 给出的规范进行。
2.性能测试
- 定量方法:固体培养基的繁殖率通过EN ISO 11133 中所述的定量方法加以定量。
- 定性方法繁殖率、特异性和选择性通过EN ISO 11133 中所述的方法加以定性。
制备和测试的所有培养基均符合所要求的繁殖率、选择性和特异性的标准(适用情况下)。定量繁殖率测试结果符合所要求的标准:选择性培养基的繁殖率(PR)≥ 50%,非选择性培养基的PR ≥ 70%。表5和表6给出了研究中获得的结果。对使用质量控制实验室所使用的去离子水以及Milli-Q® IX系统纯化的水制备的培养基进行定性和定量测试得出的结果符合标准要求。
选择用于培养基制备的水溶液
当通过将脱水培养基溶于水中来制备培养基时,选择正确的水质非常重要,因为水可能会含有杂质,这些杂质会影响培养基的繁殖率或引起异常,例如EN ISO 11133标准1的附录H所列出的不正确的pH值、错误的颜色或沉淀等。此标准的水质要求请见表 1。该标准的一个附注表明,通过离子交换树脂的水(去矿物质或去离子的水)可能具有很高的微生物含量。因此不建议未先检查微生物含量就使用这些水源。该标准警告,被高度污染的去矿物质的水,即便使用过滤器做过消毒,仍可能含有会抑制特定微生物生长的物质。
使用Milli-Q® IX纯水系统进行微生物培养基制备和性能测试的适用性
本研究证明,用Milli-Q® IX系统的产水制备的培养基的特性和性能,可与使用获得认证的QC实验室常规使用的中央纯化去离子水制备的培养基相媲美。这表明,只要按照EN ISO 11133标准制备培养基时,就可以放心地使用Milli-Q® IX纯水系统的产水。Milli-Q® 系统可用于手动准备培养基,或与创新的自动化仪器结合使用,例如 ReadyStream® 系统,通过制备和分配预热的培养基来简化流程。
安装有0.22 µm终滤器的Milli-Q® IX纯水系统所纯化的水,经过验证可提供满足或超过EN ISO 11133标准的水质要求的纯水(表 1)。其他标准和方法,例如美国公共卫生协会(APHA)标准方法,5 提出了关于水质和纯化技术的具体建议,Milli-Q® IX系统的设计和性能均符合该标准的要求。建议该系统组合使用各种纯水生产技术,包括电阻率监测装置、以及配有紫外线照射装置的蓄水箱。Milli-Q® IX系统的产水电导率低于0.2 µS/cm,微生物水平低于102 cfu/mL,不含可能会抑制微生物生长的微量污染物,例如氯素、氨和金属等。该系统的产水符合EN ISO 11133 的水质要求,因此它将有助于确保实验室的合规性。然而,重要的是还要确保这种水适用于制备微生物培养基。
Milli-Q® IX 系统设计确保纯水质量稳定
使用质量一致的纯水制备培养基,是获得准确且可再现结果的重要条件。Milli-Q® IX 系统可产出水质稳定的纯水,并通过以下几个关键功能来保证储水纯度:
- 系统纯化后的水储存在优质聚乙烯储水箱中,不会有溶出物释放到水中
- 该储水箱由通风过滤器保护,防止空气中的污染物进入。
- 纯水在 UVC LED 灭菌灯灯上方自动循环,而且在系统的取水点装有0.22 µm滤网,确保了可靠的低微生物水平。
- 系统中包含的 Elix®电去离子模块可确保水质恒定,尤其是电导率6
EN ISO 11133 标准中强调的重要水质参数包括低储水箱溶出物含量、低微生物含量以及稳定的低电导率。拥有可靠且独立的鲜制纯水水源,可防止由于制造局限性或维护工作而导致水质意外变化或者中央回路出现无法按时供水的风险。
使用Milli-Q® IX纯水系统进行微生物培养基制备和性能测试的优势
使用Milli-Q® IX纯水系统为微生物测试实验室带来了诸多好处。
- 根据EN ISO 11133标准,使用纯水前应检查纯水的电导率(或其倒数电阻率)。Milli-Q® IX纯水系统让用户可线上精确测量水电阻率,并将其显示在E-POD® 取水臂界面上,监控更加方便。通过戴着手套也可以操作的直观触摸屏,可以轻松查检水质参数。
- E-POD®取水臂不仅可以节省时间,而且取水精度高,取水 流量可以轻松地适应实验需求,显示屏让用户能够对要取用的特定体积进行编程。不仅如此,取水臂带来 灵活性 ,因为它既可以在水槽上方使用,又可以固定在支撑臂上往较大容器内加水。
- 此外,还可以加装一个 脚踏板 ,从而方便一连串的取水操作,同时解放双手做别的工作。
- 实验室的任何人员都可以轻松完成常规的系统维护,为了确保系统最佳运行,也可以由服务工程师完成。
- 该系统还保存与水质参数有关的所有数据以及耗材更换和其他服务活动等信息,实现了数据可追溯性以及无纸化数据管理。数据检索简单易行,简化了实验室的审核准备工作。还可以使用网上服务来存储所有文件,并启用网上服务合同管理。
- 为额外提升效率,该系统也可用作 ReadyStream® 系统的直接水源, 以便于随时随地在15分钟内制备大量预热的培养基(多达100升)。该系统所生产的纯水亦可用于其他任务,例如冲洗玻璃器皿,给高压灭菌釜或洗瓶机供水。这使得Milli-Q® IX系统成为微生物实验室的一个综合性解决方案。

此研究结果表明,使用Milli-Q®IX纯水系统的产水所制备的培养基的性能,可以媲美使用实验室常规中央纯化去离子水所制备的培养基的性能。Milli-Q®纯水系统使实验室能够制备性能符合标准要求的培养基,同时还具有其他一些好处,例如使用简单方便、数据可追溯和自治。这些功能相结合,可实现高效的纯水系统管理、可靠的水纯度并提高实验室效率,帮助科学家保持理想工作效率。
参考文献
产品
如要继续阅读,请登录或创建帐户。
暂无帐户?